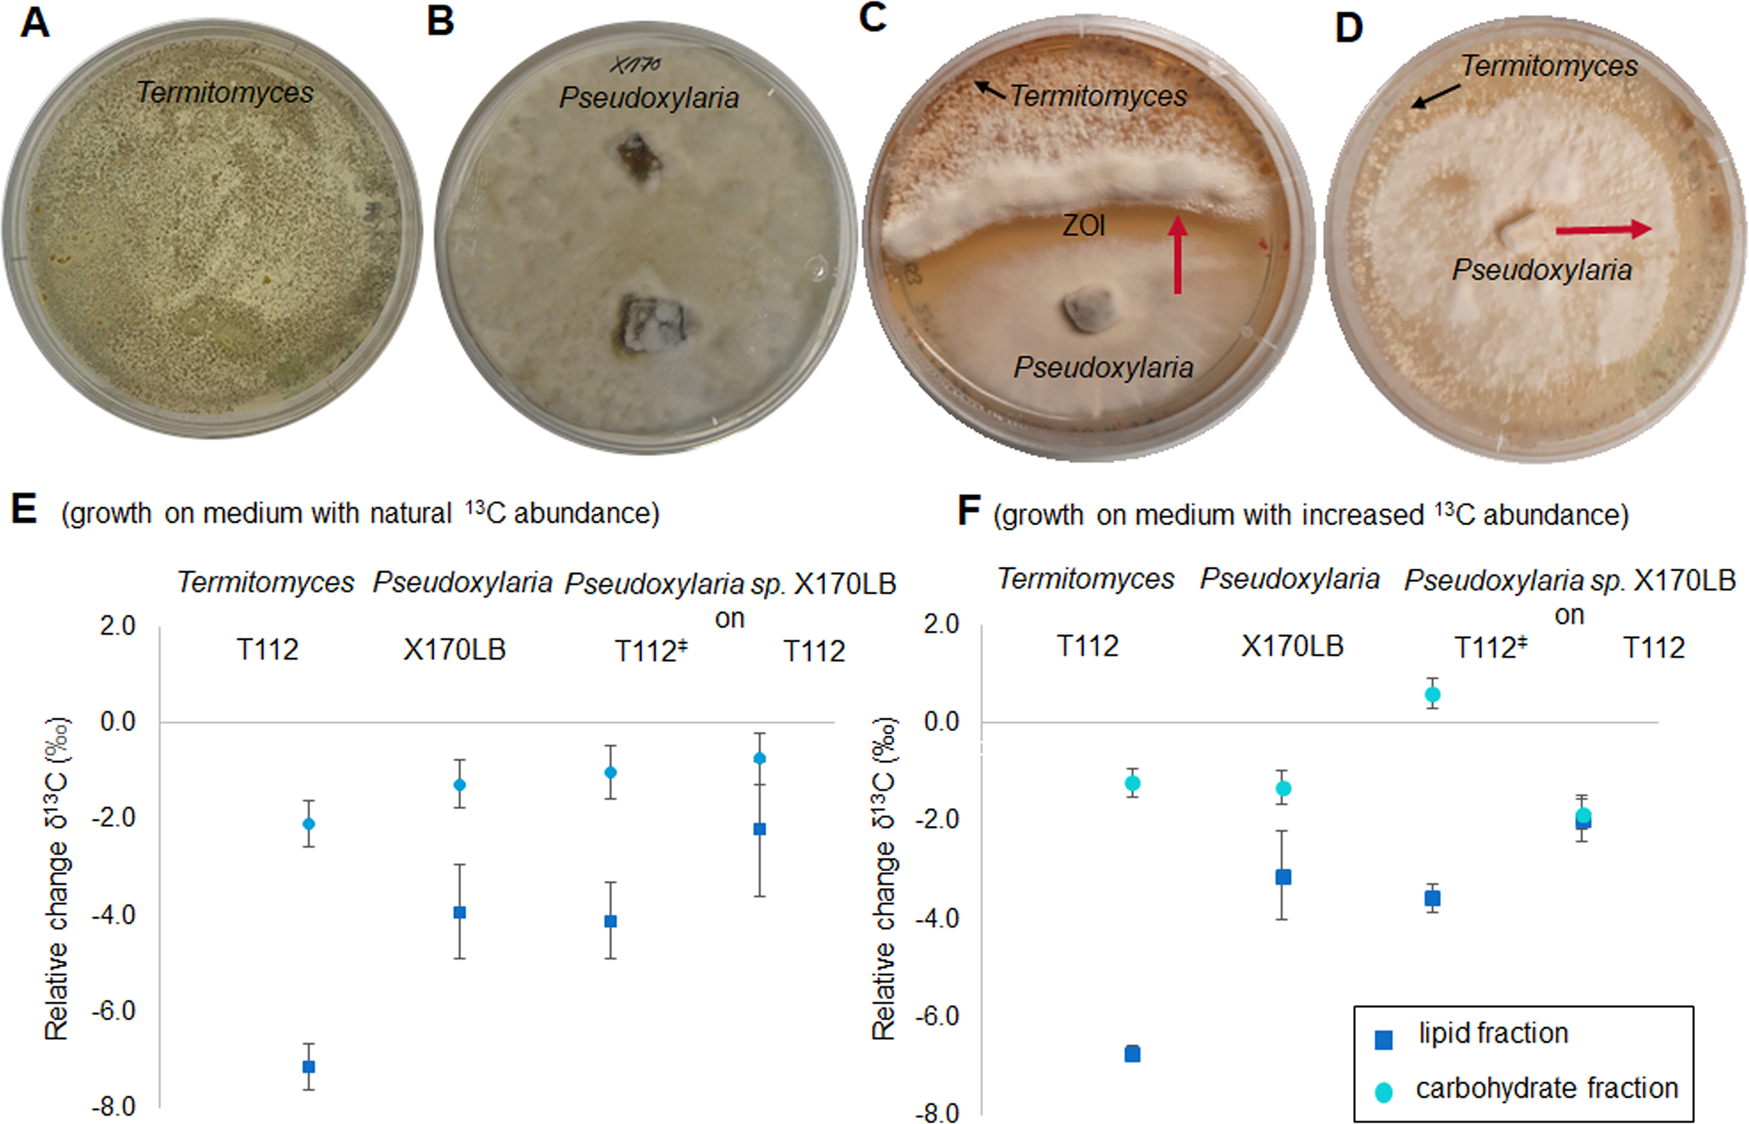
Fig. 6

Fig. 6: Co-cultivation of Pseudoxylaria sp. X170LB and Termitomyces sp. T112 and results of isotope fractionation experiments.
From: Adaptations of Pseudoxylaria towards a comb-associated lifestyle in fungus-farming termite colonies
Representative pictures of fungal growth and co-cultivation of A Termitomyces sp. T112, B Pseudoxylaria sp. X170LB, C co-culture of Pseudoxylaria sp. X802 and Termitomyces sp. T153 exhibiting a ZOI, in which X802 overgrowths T153 in proximity to the interaction zone (red arrow), and D Pseudoxylaria sp. X802 growing on the surface of a living Termitomyces sp. T153 culture. E, F Shown is the relative change in the carbon isotope pattern (δ13C values, ± standard deviation, with n = 3) of lipid and carbohydrate fractions isolated from fungal biomass of Termitomyces sp. T112, Pseudoxylaria sp. X170LB, and Pseudoxylaria sp. X170LB cultivated on vegetative Termitomyces sp. T112 biomass (T112ǂ), or on lyophilized Termitomyces sp. T112 biomass (T112). Fungal strains were grown on E medium with natural 13C abundance and F medium artificially enriched in 13C content.